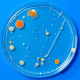

La prise en charge de la vaccination contre le zona évolue
16 DÉCEMBRE 2024
16 DÉCEMBRE 2024
Le zona est une maladie infectieuse virale qui se caractérise souvent par des douleurs et l’apparition au niveau du thorax de petits boutons pouvant démanger. À compter du 14 décembre 2024, le vaccin contre le zona est remboursé par l’Assurance maladie à hauteur de 65 % pour les 65 ans et plus ainsi que pour les personnes immunodéprimées ayant au moins 18 ans. Le zona peut avoir des conséquences particulièrement nocives lorsqu’il survient chez ces personnes.
Le zona est due à la réactivation du virus varicelle-zona. Après la guérison d’une varicelle, le virus varicelle-zona reste endormi ; des années plus tard il peut se réactiver et entraîner l’apparition d’un zona. Vous allez alors ressentir de fortes douleurs et des petits boutons vont apparaître sur une zone bien délimitée de votre corps. Ces vésicules peuvent notamment se manifester au niveau de :
Le zona guérit en général en 2 à 3 semaines. Cependant des complications, notamment des douleurs intenses et persistantes qui nuisent à la vie de tous les jours, sont possibles, en particulier chez les personnes âgées et/ou immunodéprimées.
À compter du 14 décembre 2024, le vaccin Shingrix contre le zona est remboursé à 65 % par l’Assurance maladie pour :
Ces 2 catégories de personnes pouvaient déjà bénéficier depuis mai 2024 d’une prise en charge par l’Assurance maladie de cette vaccination, mais uniquement si cela se déroulait au sein de certains établissements de santé (centres hospitaliers, centres hospitaliers régionaux…).
À noter : L’Assurance maladie présente différentes mesures qui peuvent soulager vos symptômes, en particulier la douleur, si vous êtes atteint de zona. Il est notamment recommandé de :
- Prendre des douches ou des bains, 2 fois par jour, à l’eau tiède et utiliser un savon surgras
- Appliquer, si possible, des pansements simples sur les lésions du zona
Il est par ailleurs conseillé de consulter votre médecin traitant pour confirmer le diagnostic de zona et adapter le traitement à votre cas.
Attention : Si vous êtes enceinte, vous devez éviter tout contact avec une personne ayant la varicelle ou un zona. Si vous avez été en contact avec une personne atteinte d’une de ces maladies dans un délai inférieur à 96 heures, il est recommandé d’en parler à votre médecin afin qu’il puisse vérifier si vous êtes immunisée.
Vous trouverez ci-dessous le lien pour accéder à l’article officiel sur le site du Service Public :
Vous souhaitez rester informés des dernières actualités concernant la biologie médicale ?
Le rôle des URPS dans la gestion de la santé régionale : Focus sur les biologistes...
Le rôle des URPS dans la gestion de la santé régionale : Focus sur les biologistes...